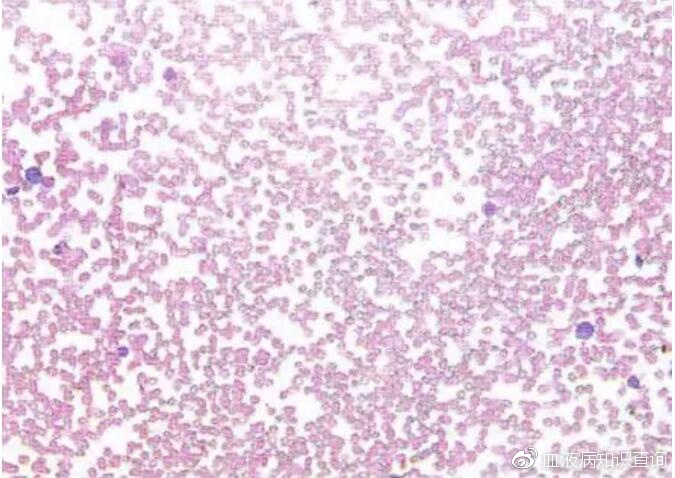
再障性贫血的骨髓涂片,你认识吗?

骨髓小粒空虚

骨髓小粒
图片尺寸268x244
再障性贫血的骨髓涂片,你认识吗?
图片尺寸675x478
骨髓小粒
图片尺寸650x484
帮忙看一下骨髓细胞这是什么情况
图片尺寸3456x4608
好的骨髓图片
图片尺寸1024x768图 6行染色镜检,可见较多的破骨细胞,肥大细胞,浆细胞,骨髓小粒较空
图片尺寸712x784
好的骨髓图片
图片尺寸1280x960
好的骨髓图片
图片尺寸1280x960
课程讲义
图片尺寸433x192
正常骨髓(图片)
图片尺寸504x331一文了解 | 脊髓空洞症临床及影像学表现
图片尺寸720x1280
【医学科普】脊髓空洞症你了解多少?
图片尺寸400x300骨髓稀释标本一个隐藏的小偷
图片尺寸396x297
诊断脊髓空洞症能否成立?
图片尺寸2304x3072
好的骨髓图片
图片尺寸1280x960
好的骨髓图片
图片尺寸1280x960骨髓稀释标本一个隐藏的小偷
图片尺寸396x297
脊髓空洞 - 好大夫在线
图片尺寸600x494
好的骨髓图片
图片尺寸1024x768
图425 请指出图中箭头所指物名称(骨髓 10×40 瑞氏染色)
图片尺寸856x612